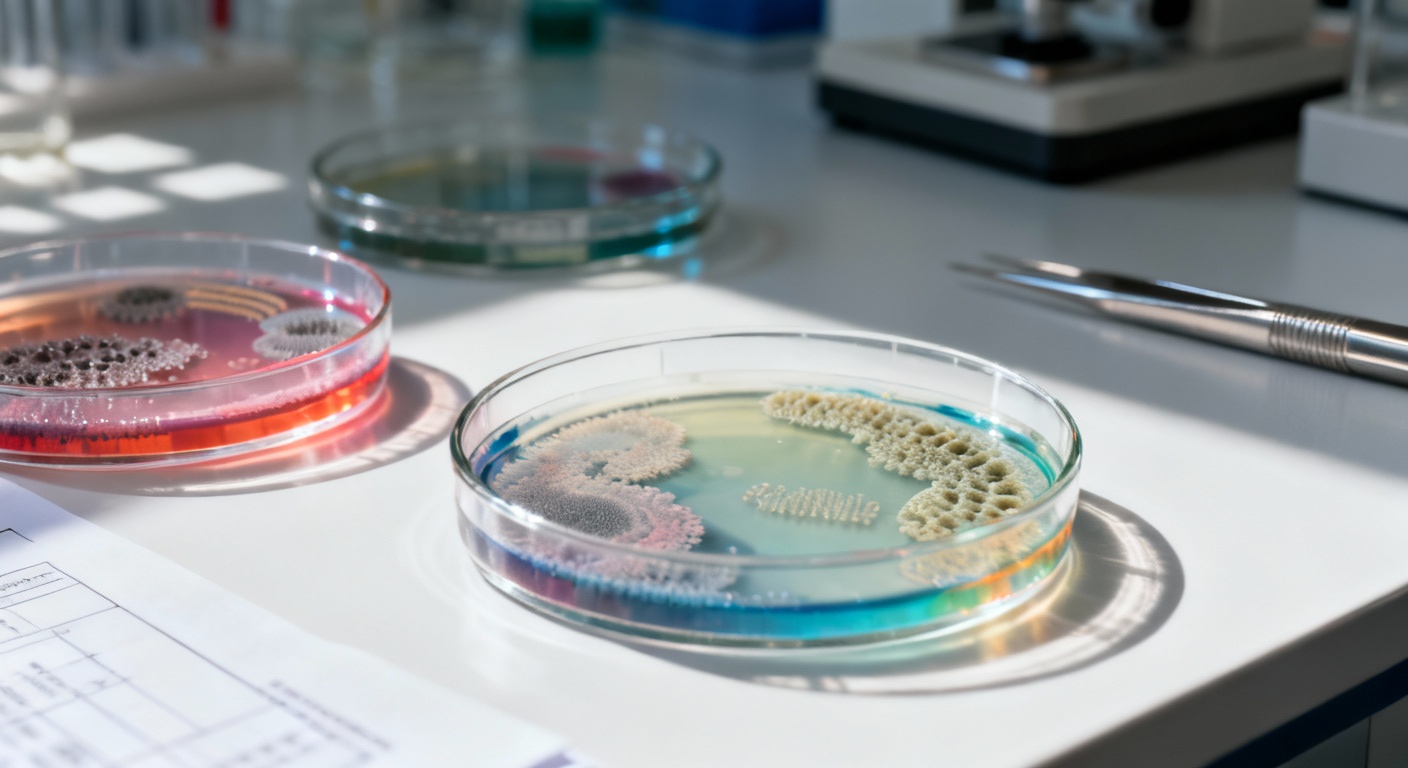

Ce complément alimentaire courant pourrait bien freiner le cancer colorectal (et c’est une bonne nouvelle)
Auteur: Mathieu Gagnon
Une découverte qui change la donne dans nos intestins

On entend tout et son contraire sur les compléments alimentaires, n’est-ce pas ? Mais parfois, une étude sort du lot et nous force à prêter attention. C’est exactement ce qui se passe avec ces nouvelles données cliniques, publiées autour du 18 décembre 2025 par le Vanderbilt University Medical Center. Tom Wilemon nous rapporte qu’un supplément que beaucoup d’entre nous ont probablement déjà dans leur armoire à pharmacie pourrait modifier les microbes de notre intestin.
Et pas n’importe comment. Il s’agit du magnésium. Les chercheurs ont démontré, grâce à un essai clinique de précision, que la prise de magnésium peut augmenter certaines bactéries intestinales chez l’homme. Ces petites bêtes sont connues pour produire de la vitamine D et jouer un rôle crucial pour limiter le développement du cancer colorectal. C’est assez fascinant quand on y pense : le magnésium boosterait la production de vitamine D directement dans l’intestin, où elle agit localement, plutôt que de simplement passer dans le sang.
Génétique, œstrogènes et mécanisme d’action : pourquoi tout le monde ne réagit pas pareil

Il y a un détail curieux dans cette histoire… L’effet a été observé principalement chez les femmes. Les chercheurs, toujours à l’affût d’une explication, suggèrent que cette différence pourrait être liée aux œstrogènes. Il semblerait que ces hormones influencent la façon dont le magnésium se déplace du sang vers les cellules. Mais ce n’est pas tout. La génétique s’en mêle aussi pour déterminer qui en profite le plus.
Pour y voir plus clair, l’équipe a examiné les données du microbiome intestinal et les résultats de coloscopies de participants regroupés selon leur génotype TRPM7. Ce gène, dont je n’avais jamais entendu parler avant, est apparemment essentiel pour contrôler la façon dont notre corps absorbe le magnésium et le calcium. Dans des travaux antérieurs issus du même essai randomisé, les enquêteurs avaient trouvé que le magnésium augmentait la production de vitamine D et ses niveaux dans le sang.
Mais là, les nouveaux résultats indiquent quelque chose de plus subtil : le magnésium favorise aussi la production de vitamine D directement à l’intérieur de l’intestin. Cette vitamine D produite localement n’entre pas dans la circulation sanguine ; elle agit là où elle est fabriquée. Ces résultats, issus de l’essai nommé Personalized Prevention of Colorectal Cancer Trial, ont été récemment publiés dans The American Journal of Clinical Nutrition en novembre 2025 (DOI: 10.1016/j.ajcnut.2025.09.011).
Bactéries et résultats cliniques : Plongée au cœur de l’étude
Le Dr Qi Dai, MD, PhD et professeur de médecine, explique que leur précédente étude montrait que la supplémentation en magnésium augmentait les niveaux sanguins de vitamine D quand ceux-ci étaient bas. « L’étude actuelle révèle que la supplémentation en magnésium augmente aussi les microbes intestinaux, qui ont montré qu’ils synthétisent la vitamine D dans l’intestin sans lumière du soleil et inhibent localement le développement du cancer colorectal », précise-t-il.
Concrètement, comment ça s’est passé ? Les participants ont été divisés en deux groupes : l’un recevant le supplément de magnésium, l’autre un placebo. Leur microbiome intestinal a été analysé à partir de selles, d’écouvillons rectaux et de tissus rectaux. C’est là que ça devient un peu technique, accrochez-vous. Chez les participants avec une fonction TRPM7 adéquate, le magnésium a augmenté la présence de Carnobacterium maltaromaticum et de Faecalibacterium prausnitzii. Ces deux-là travaillent en synergie pour augmenter la vitamine D et diminuer la carcinogenèse colorectale.
Par contre, chez ceux avec une fonction TRPM7 inadéquate, le supplément a réduit l’abondance de F. prausnitzii dans la muqueuse rectale. Et c’est important. Pourquoi ? Sur les 236 participants (qui avaient tous des antécédents de polypes colorectaux), 124 ont subi des coloscopies après l’essai, avec un suivi médian de 3,5 ans. Une abondance plus élevée de F. prausnitzii dans la muqueuse rectale était associée à une augmentation de presque trois fois le développement de polypes supplémentaires. Donc, réduire cette bactérie chez les personnes à risque (TRPM7 inadéquat) grâce au magnésium semble être une stratégie gagnante.
Conclusion : Vers une prévention sur mesure

En fin de compte, ces découvertes suggèrent que le traitement par supplémentation en magnésium pourrait diminuer le risque de cancer colorectal chez les individus ayant une fonction TRPM7 inadéquate. Tout cela fournit de nouvelles perspectives sur les interactions entre la nutrition et le microbiome intestinal contribuant à la carcinogenèse, et établit les bases d’une stratégie de précision pour la prévention chez les populations à haut risque.
Il faut saluer le travail titanesque des auteurs : Elizabeth Sun, Xiangzhu Zhu, Reid M. Ness, M. Andrea Azcarate-Peril, Martha J. Shrubsole et Qi Dai. Les chercheurs ont reçu le soutien du National Cancer Institute (subventions R01 DK110166, R01 CA149633 et R03 CA 189455) et du fonds de dotation du Vanderbilt-Ingram Cancer Center. Dai et Martha Shrubsole (professeure de recherche sur le cancer Ingram) sont les investigateurs principaux de la subvention qui a financé cette recherche sur le microbiome auprès du National Institute of Diabetes and Digestive and Kidney Diseases (DK110116).
Ce contenu a été créé avec l’aide de l’IA.